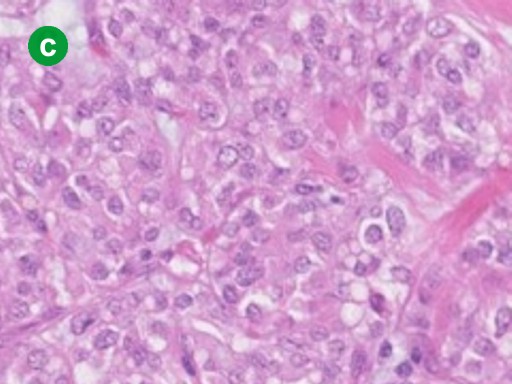

CASE REPORT
JOP. J Pancreas (Online) 2010 Jan 8; 11(1):45-48.
Solid Pseudopapillary Tumor of the Pancreas with Concomitant Pancreas Divisum. A Case Report
Daisuke Watanabe1, Kouichi Miura2, Takashi Goto2, Hiroshi Nanjo3, Yuzo Yamamoto4, Hirohide Ohnishi2
1Department of Gastroenterology, Noshiroyamamoto Medical Association Hospital. Noshiro, Japan. Departments of 2Gastroenterology, 3Pathology, and 4Gastroenterological Surgery, Akita University Graduated School of Medicine. Akita, Japan
ABSTRACT
Context Solid pseudopapillary tumor of the pancreas is a rare neoplasm which affects young women. On the other hand, pancreas divisum is an anomaly which develops at 7 weeks of gestation. Here, we report a case of a solid pseudopapillary tumor of the pancreas with concomitant pancreas divisum. Case report A 26-year-old woman was diagnosed as having a pancreatic tumor with solid and cystic components in the pancreatic head. Pancreatograms obtained by ERCP and MRCP showed no communication between the ventral and dorsal pancreatic ducts, indicating that pancreas divisum was present. Microscopically, the resected tumor had solid and cystic components. Immunohistochemical study demonstrated that the tumor cells were positive for alpha-1-antitrypsine, vimentin and progesterone receptor but negative for estrogen receptors, NSE, insulin or glucagon. The tumor was diagnosed as a solid pseudopapillary tumor of the pancreas. Although more than 700 cases of solid pseudopapillary tumors of the pancreas have been reported in the English literature, a search of PubMed turned up no reports of concomitant solid pseudopapillary tumor and pancreas divisum. Conclusion Solid pseudopapillary tumors of the pancreas with concomitant pancreas divisum are extremely rare.
INTRODUCTION
Solid pseudopapillary tumors of the pancreas are rare pancreatic neoplasms accounting for 0.13% to 2.7% of all pancreatic tumors [1]. Frantz first described the unique characteristics of this tumor in 1959 [2], and then Klöppel et al. clearly documented this distinct clinical entity in 1981 [3]. Due to its variety of gross appearances and histological features, this tumor has been referred to with multiple names such as papillary cystic neoplasm, solid and papillary epithelial neoplasm, and papillary and solid neoplasm. This tumor is currently designated as a solid pseudopapillary tumor of the pancreas by WHO [4].
In contrast to pancreatic cancer, a solid pseudopapillary tumor of the pancreas primarily affects young females, suggesting that this tumor is associated with some female hormones and their receptors. In addition, solid pseudopapillary tumors are occasionally found as extra- pancreatic tumors, indicating that the origin of the tumor cells is distinct from other pancreatic tumors. Although many investigators have proposed the origin of solid pseudopapillary tumors of the pancreas, including pluripotent stem cells, ductal cells, acinar cells, neuroendocrine cells, neurocrest and ovaries [1, 5], the origin of the tumor cells and promoting factors have not yet been determined.
Pancreas divisum is an anomaly caused by inappropriate fusion of the dorsal and the ventral pancreatic ducts during embryogenesis. Recent data have shown that pancreas divisum is highly associated with pancreatic tumors [6]. One of the proposed mechanisms by which pancreatic tumors occur in patients with divisum is recurring pancreatitis. Chronically damaged pancreatic cells may transform into cells having a malignant potential. However, the association between solid pseudopapillary tumor and pancreas divisum is still unknown. We herein report the case of a solid pseudopapillary tumor of the pancreas with concomitant divisum in the same pancreas.
CASE REPORT
A 26-year-old woman, who had complained of intermittent abdominal pain for 8 years, was referred to our hospital for further evaluation of a pancreatic tumor. She was 159 cm tall and weighed 48 kg. Her pulse rate was 70 min-1 and her blood pressure was 120/80 mmHg. There was no evidence of jaundice. The abdomen was flat and soft but tenderness was present at the upper abdomen. The tumor was not palpable. Other physical examinations were unremarkable. Laboratory data including hematology, blood chemistry including amylase and lipase, and tumor markers including CEA and CA 19-9 were within the reference limits. US imaging showed a pancreatic tumor with solid and cystic components (Figure 1a). A CT scan demonstrated that the well-circumscribed tumor was located in the pancreatic head (Figure 1b). Pancreatograms obtained by MRI and ERCP showed no communication between the tumor and the pancreatic duct. In addition, the ventral pancreatic duct did not communicate with the dorsal pancreatic duct (Figure 2ab). Duodenum-preserving pancreatic head resection was performed [7, 8]. Briefly, the subtotal pancreatic head was resected preserving the bile duct. Reconstitution with drainage of the pancreatic secretion from the remnant pancreas took place with Roux-en Y end-to-side pancreaticojejunostomy. The resected tumor was 50x45x52 mm in size and 50 g in weight, accompanied by hemorrhagic degeneration and surrounded by a red fibrotic pseudocapsule (Figure 3a). Microscopically, the tumor had a cystic component (Figure 3b). The tumor cells were small to intermediate in size with faintly eosinophilic cytoplasm. The nuclei had slight indentations and no mitosis (Figure 3c). Immunohistochemical examination demonstrated that the tumor cells were positive for the progesterone receptor (Figure 3d). In addition, the tumor cells were also stained with alpha-1-antitrypsine and vimentin but not with estrogen receptors, NSE, insulin or glucagon (data not shown).


|
Figure 1. a. Abdominal US. The tumor has solid (arrow) and cystic components (arrowhead). b. CT scan. The tumor is well encapsulated with peripheral enhancement (arrow). |
|
|


|
Figure 2. a. MRCP. The ventral pancreatic duct does not communicate with the dorsal pancreatic duct. b. ERCP. The ventral duct attenuates and ends at the pancreatic body. In addition, the ventral pancreatic duct does not communicate with the dorsal pancreatic duct. |
|
|

|
Figure 3. a. Gross appearance. The tumor is a well-circumscribed solid mass. Hemorrhagic degeneration is seen (arrow). b. A low power view shows the tumor having cystic components (arrowheads). (H&E, magnification x100, Bar, 200µm). c. A high power view demonstrates that the tumor cells, faintly eosinophilic cytoplasm, have slight indentations and no mitosis of nuclei. (H&E, magnification x400). d. Immunohistochemistry. The tumor cells are positive for progesterone receptor (Magnification x400). |
|
|
DISCUSSION
A solid pseudopapillary tumor of the pancreas primarily affects young women, suggesting that hormonal factors contribute to the tumor growth. In the present case, abdominal symptoms were noted at 16 years of age, at which age female hormones and their receptors function. Progesterone, estrogen, and their receptors might play a role in the development of solid pseudopapillary tumor of the pancreas. Our case showed that the tumor cells were positive for the progesterone receptor but negative for estrogen receptors according to an immunohistochemical study. Large clinical studies show that the progesterone receptor is expressed by all cases of solid pseudopapillary tumors [9, 10]. In addition, Yeh et al. have reported that the progesterone receptor is uniquely expressed in solid pseudopapillary tumors while both estrogen and progesterone receptors are expressed in mucinous cystic neoplasm [9]. These clinical and histological findings imply that progesterone and its receptor contribute to tumor growth.
Why do pancreatic tumors express the progesterone receptor? The hypothesis proposed by Zamboni et al. is an excellent explanation for pancreatic tumors which primarily affect women [11]. Pancreatic anlages are very close to the genital ridge during embryogenesis. Primitive ovarian tissue may be incorporated into pancreatic tissue during the process of pancreatic fusion, after which dislocated ovarian tissue may start growing in response to female hormones during adolescence. Indeed, immunoprofiles of pancreatic tumors which affect women are similar to those in certain ovarian tumors [10, 11]. Ten percent of solid pseudopapillary tumors of the pancreas affect men, in whom the solid pseudopapillary tumors also express the progesterone receptor [10]. Even in men, progesterone is produced by the adrenal glands and testes. However, the origin of male solid pseudopapillary tumors might be different from that of females. Further studies are necessary to elucidate the origin of solid pseudopapillary tumor.
Interestingly, the present case had pancreas divisum, an anomaly which develops at 7 weeks of gestation. Pancreas divisum is associated with pancreatic carcinoma due to recurring pancreatitis [6]. However, the present case had no histological evidence of pancreatitis, indicating that chronic pancreatitis does not account for the development of solid pseudopapillary tumors. Although more than 700 cases of solid pseudopapillary tumors of the pancreas have been reported in the English literature [12], a search of PubMed turned up no reports of concomitant solid pseudopapillary tumors and pancreas divisum in the same pancreas. Therefore, the association between solid pseudopapillary tumors of the pancreas and divisum is currently unknown.
In summary, we have reported a rare case of a solid pseudopapillary tumor of the pancreas with concomitant divisum. Little information is currently available on the association between pancreatic solid pseudopapillary tumor and divisum.
Accepted October 3rd, 2009 - Received November 2nd, 2009
Key words Neoplasms /etiology; Progesterone
Acknowledgement We thank Kazuo Yoneyama, Akita Kumiai General Hospital and Shigetoshi Ohshima, Wataru Sato,Takahiro Dohmen, Akita University Graduated School of Medicine, for preparation of the present manuscript
Conflict of interest The authors have no potential conflicts of interest
Correspondence
Kouichi
Miura
Akita University Graduated School of Medicine
Department of Gastroenterology
1-1-1 Hondo Akita-shi
Akita 010-8543
Japan
Phone: +81.18.884.6104
Fax: +81-18.836.2611
E-mail: miura116@doc.med.akita-u.ac.jp
References
1. Mortenson MM, Katz MH, Tamm EP, Bhutani MS, Wang H, Evans DB, et al. Current diagnosis and management of unusual pancreatic tumors. Am J Surg 2008; 196:100-13. [PMID 18466869] (Full text)
2. Frantz VK. Tumor of the pancreas. In: Atlas of Tumor Pathology. Section 7, fascicles 27 and 28. Washington, DC, USA: Armed Forces Institute of Pathology; 1959:32-3.
3. Klöppel G, Morohoshi T, John HD, Oehmichen W, Opitz K, Angelkort A, et al. Solid and cystic acinar tumor of the pancreas. Virchows Arch A Pathol Anat Histol 1981; 392:171-83. [PMID 7281507]
4. Kloppel G, Solcia E, Longnecker D, Capella C, Sobin LH, editors. Histological typing of tumours of the exocrine pancreas. WHO International Histological Classification of Tumours. 2nd ed. Berlin: Springer; 1996.
5. Kallichanda N, Tsai S, Stabile BE, Buslon V, Delgado DL, French SW. Histogenesis of solid pseudopapillary tumor of the pancreas: the case for the centroacinar cell of origin. Exp Mol Pathol 2006; 81:101-7. [PMID 16916512] (Full text)
6. Kamisawa T, Yoshiike M, Egawa N, Tsuruta K, Okamoto A, Funata N. Pancreatic tumor associated with pancreas divisum. J Gastroenterol Hepatol 2005; 20:915-8. [PMID 15946141] (Full text)
7. Büchler MW, Friess H, Bittner R, Roscher R, Krautzberger W, Müller MW, et al. Duodenum-preserving pancreatic head resection: Long-term results. J Gastrointest Surg 1997; 1:13-9. [PMID 9834325] (Full text)
8. Ito K. Duodenum preservation in pancreatic head resection to maintain pancreatic exocrine function (determined by pancreatic function diagnostant test and cholecystokinin secretion). J Hepatobiliary Pancreat Surg 2005; 12:123-8. [PMID 15868075] (Full text)
9. Yeh TS, Jan YY, Chiu CT, Ho YB, Chen TC, Lee KF, et al. Characterisation of oestrogen receptor, progesterone receptor, trefoil factor 1, and epidermal growth factor and its receptor in pancreatic cystic neoplasms and pancreatic ductal adenocarcinoma. Gut 2002; 51:712-6. [PMID 12377812] (Full text)
10. Kosmahl M, Seada LS, Jänig U, Harms D, Klöppel G. Solid-pseudopapillary tumor of the pancreas: its origin revisited. Virchows Arch 2000; 436:473-80. [PMID 10881741] (Full text)
11. Zamboni G, Scarpa A, Bogina G, Iacono C, Bassi C, Talamini G, et al. Mucinous cystic tumors of the pancreas: clinicopathological features, prognosis, and relationship to other mucinous cystic tumors. Am J Surg Pathol 1999; 23:410-22. [PMID 10199470] (Full text)
12. Papavramidis T, Papavramidis S. Solid pseudopapillary tumors of the pancreas: review of 718 patients reported in English literature. J Am Coll Surg 2005; 200:965-72. [PMID 15922212] (Full text)